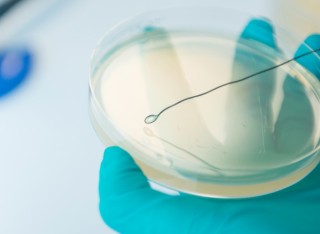

Research at the University of Surrey
The University of Surrey is a world-class, research-led university committed to research excellence. Our research seeks to answer global challenges, drive innovation and deliver real-world impact.
Within this section, you will find information on our research themes along with our newly launched Research and Innovation Strategy. We’re always looking to expand our research partnerships.
Research story highlights
Find how our research is changing the world for the better.
Our vision
Research is at the heart of our mission to create new knowledge and innovate for the benefit of society.
How we are making a difference
Unlock your research potential
Join like-minded academics and students changing the world of tomorrow.

Doctoral College
We support the academic and professional development of postgraduate researchers and early career researchers, to ensure our world-leading research continues to grow.
Stay connected
Latest tweets
@SurreyResearch

Looking for a short-term post? #Surrey is currently advertising for a #Student #Enterprise #Manager! The role consi… https://t.co/GWV48Huqf6

Join us at 4pm on 26th Jan for ULYSSES event No.7 - Streets Reconsidered by @danieliacofano & @CRJonesPsych,… https://t.co/bxiR4pvsmS

Proud to share “Connecting Capabilities, Innovate and Grow with @UniOfSurrey . Featuring high-tech, high-growth SME… https://t.co/VRkIVhfuz1